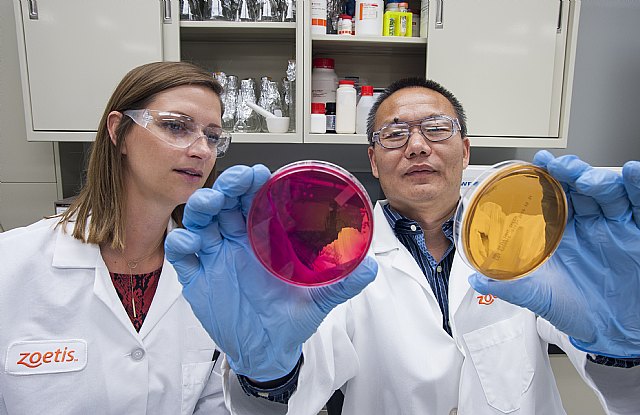
Zoetis crece por séptimo año consecutivo y se mantiene a la cabeza del sector salud animal a nivel mundial - 1, Foto 1

El sector de animales de compañía sigue creciendo a gran velocidad (+23 % a nivel operacional), con unos ingresos consolidados el año pasado de 3.145 millones de USD (2.613 millones de USD en 2018) pasando a ser el negocio principal de la compañía.
La multinacional incrementa su rentabilidad de forma sostenida desde su escisión de Pfizer en 2013. Con un crecimiento global de ingresos a nivel operacional del 10% en 2019, y del beneficio neto ajustado operacional del 14 %.
España, con un 10 % de crecimiento operacional y ventas por valor de 114 millones de USD, sigue siendo uno de sus motores de avance, con crecimientos por encima de los obtenidos en Brasil, Canadá, China o Japón.
Las expectativas de ingresos netos de Zoetis a nivel global para 2020 se sitúan en los 6.650-6.800 millones de USD.
Con unos ingresos declarados de 6.260 millones de USD el pasado año, Zoetis crece un 10 % operacional respecto del año 2018 y presenta un beneficio neto reportado de 1.500 millones de USD (+5 % con respecto al ejercicio anterior), lo que equivale a un beneficio neto por acción diluido de 3,11 USD (+6 % en comparación con el ejercicio anterior).
La compañía, que se consolida, con siete años de crecimiento consecutivo tras su salida de Pfizer en 2013, como líder en el sector de la salud animal a nivel mundial, ha hecho públicos sus resultados financieros para el cuarto y último trimestre de 2019 y para el año completo, actualizando además sus previsiones de cara a este año 2020.
En términos de beneficio neto ajustado, en 2019 la cifra se sitúa en 1.755 millones de USD (3,64 USD por acción ajustado diluido), lo que supone un crecimiento reportado del 15 % respecto al año anterior.
Estos valores reflejan un crecimiento de ingresos a nivel operacional del 10 %, cifra que aumenta hasta el 14 % operacional cuando hablamos del beneficio neto ajustado, excluyendo en ambos casos el impacto del cambio.
En cuanto al último trimestre del año 2019, la compañía ha reportado ingresos por valor de 1.674 millones de USD, un 7 % más que el mismo periodo de 2018, con un beneficio neto reportado de 384 millones de USD (0,80 USD por acción diluido), en comparación con los 345 millones y 0,71 USD por acción diluido en 2018. En cuanto al beneficio neto ajustado en el último trimestre del año, ascendió a 440 millones de USD (0,92 USD por acción ajustado diluido), lo que supone un incremento del 15 y 16 %, respectivamente.
A nivel operacional, excluido el impacto del cambio, los ingresos para el último trimestre de 2019 aumentaron un 9 % y el beneficio neto ajustado un 13 %, respecto del mismo periodo del año 2018.
Zoetis crece en todas las especies, especialmente en animales de compañía
Según explica Kristin Peck, quien ha relevado recientemente al español Juan Ramón Alaix como CEO de la compañía, “El año pasado ha sido otro gran año para Zoetis, con un fuerte crecimiento en general y en todas las especies y países. Crecemos de nuevo por encima del mercado y fortalecemos nuestro liderazgo gracias a un sólido y diversificado portafolio y a nuestro compromiso con la innovación constante. Incrementamos además nuestro beneficio neto ajustado un 14 % a nivel operacional, cumpliendo con nuestro objetivo de incrementar nuestra rentabilidad más rápidamente que nuestros ingresos a largo plazo”.
En cuanto a 2020, la CEO de Zoetis se muestra optimista gracias al lanzamiento de nuevos productos, a la vez que la compañía sigue invirtiendo en nuevas áreas de negocio, como el diagnóstico y el área digital de análisis de datos, que complementan su portafolio de productos en todo el proceso del cuidado de la salud animal (Continuum of Care), desde la predicción (genómica), pasando por la detección (diagnóstico), hasta la prevención y el tratamiento.
El crecimiento de Zoetis en España, supera el de países como China, Canadá o Brasil
A nivel internacional (otros países más allá de EE. UU., incluyendo Europa), en 2019 Zoetis ha visto crecer sus ingresos operacionales en todos los mercados en los que opera, también en España, con un 10 % de aumento operacional, y una facturación de 114 millones de USD (110 millones en 2018). Méjico (18 %) y Reino Unido (15 %) son los países que, a nivel internacional, más han crecido, mientras que China decrece un 1 % operacional, debido, entre otros, al impacto que en este mercado ha tenido la peste porcina africana.
Para Félix Hernáez, director general y vicepresidente senior de Zoetis Europa del Sur, “El año pasado ha sido de nuevo un año de crecimiento en todos los países que componen Zoetis Europa del Sur -España, Italia, Portugal y Grecia y Balcanes-, con crecimientos respecto del ejercicio anterior de hasta el 13 % en Italia, o del 10 % en España. Un año intenso en el que hemos puesto en marcha una nueva unidad centrada exclusivamente en diagnóstico, con un nuevo equipo técnico y comercial al frente, para gestionar una amplia gama de productos que, bajo la marca VetScan, permiten el análisis in situ y en pocos minutos en la propia clínica veterinaria”.
El negocio del diagnóstico veterinario es estratégico para la compañía, ya que además de mover más de 4 000 millones de USD a nivel mundial y 50 millones de euros anuales solo en nuestro país, y de ser un mercado de gran potencial, que ha crecido por encima del 10 % en los últimos tres años, “Resulta fundamental -concluye Hernáez- como base de nuestra oferta de cuidado integral de la salud animal -Continuum of Care-. Esta capacidad de innovar en todo el proceso es precisamente una de nuestras principales ventajas competitivas”.
Los animales de compañía siguen impulsando el crecimiento de Zoetis a nivel mundial
Por segmentos, los animales de compañía siguen actuando como motor de crecimiento a nivel global, con unos ingresos consolidados de 3.145 millones de USD (2.613 millones de USD en 2018), lo que supone un incremento operacional del 23 % respecto a 2018 superando por primera vez al segmento de ganadería con 3.030 millones de USD en 2019 (decrecimiento operacional del 1 %). Destaca el vacuno con 1.654 millones de USD de facturación consolidada, seguido del porcino (611 millones de USD) y la avicultura (559 millones de USD), y la acuicultura (134 millones de USD), con un crecimiento operacional de -2, -5, 10 y 6 % respectivamente.
En cuanto a las expectativas de ingresos netos de Zoetis a nivel global para el presente año se sitúan en los 6.650-6.800 millones de USD, lo que supondría un crecimiento a nivel operacional del 7 % - 9,5 %, y un beneficio neto ajustado del 8 – 11 %.
Zoetis
Zoetis es la empresa líder de salud animal, dedicada a apoyar a sus clientes y sus negocios. Construida sobre 60 años de experiencia en salud animal, Zoetis descubre, desarrolla, fabrica y comercializa medicamentos y vacunas de uso veterinario complementados por productos de diagnóstico y apoyados por una amplia gama de servicios. En 2019, la compañía generó unos ingresos anuales de más de 6.260 millones de dólares. Con cerca de 9.000 empleados a nivel global, sus productos sirven a veterinarios, ganaderos, productores y todos aquellos que crían y cuidan el ganado y los animales de compañía en más de 100 países.